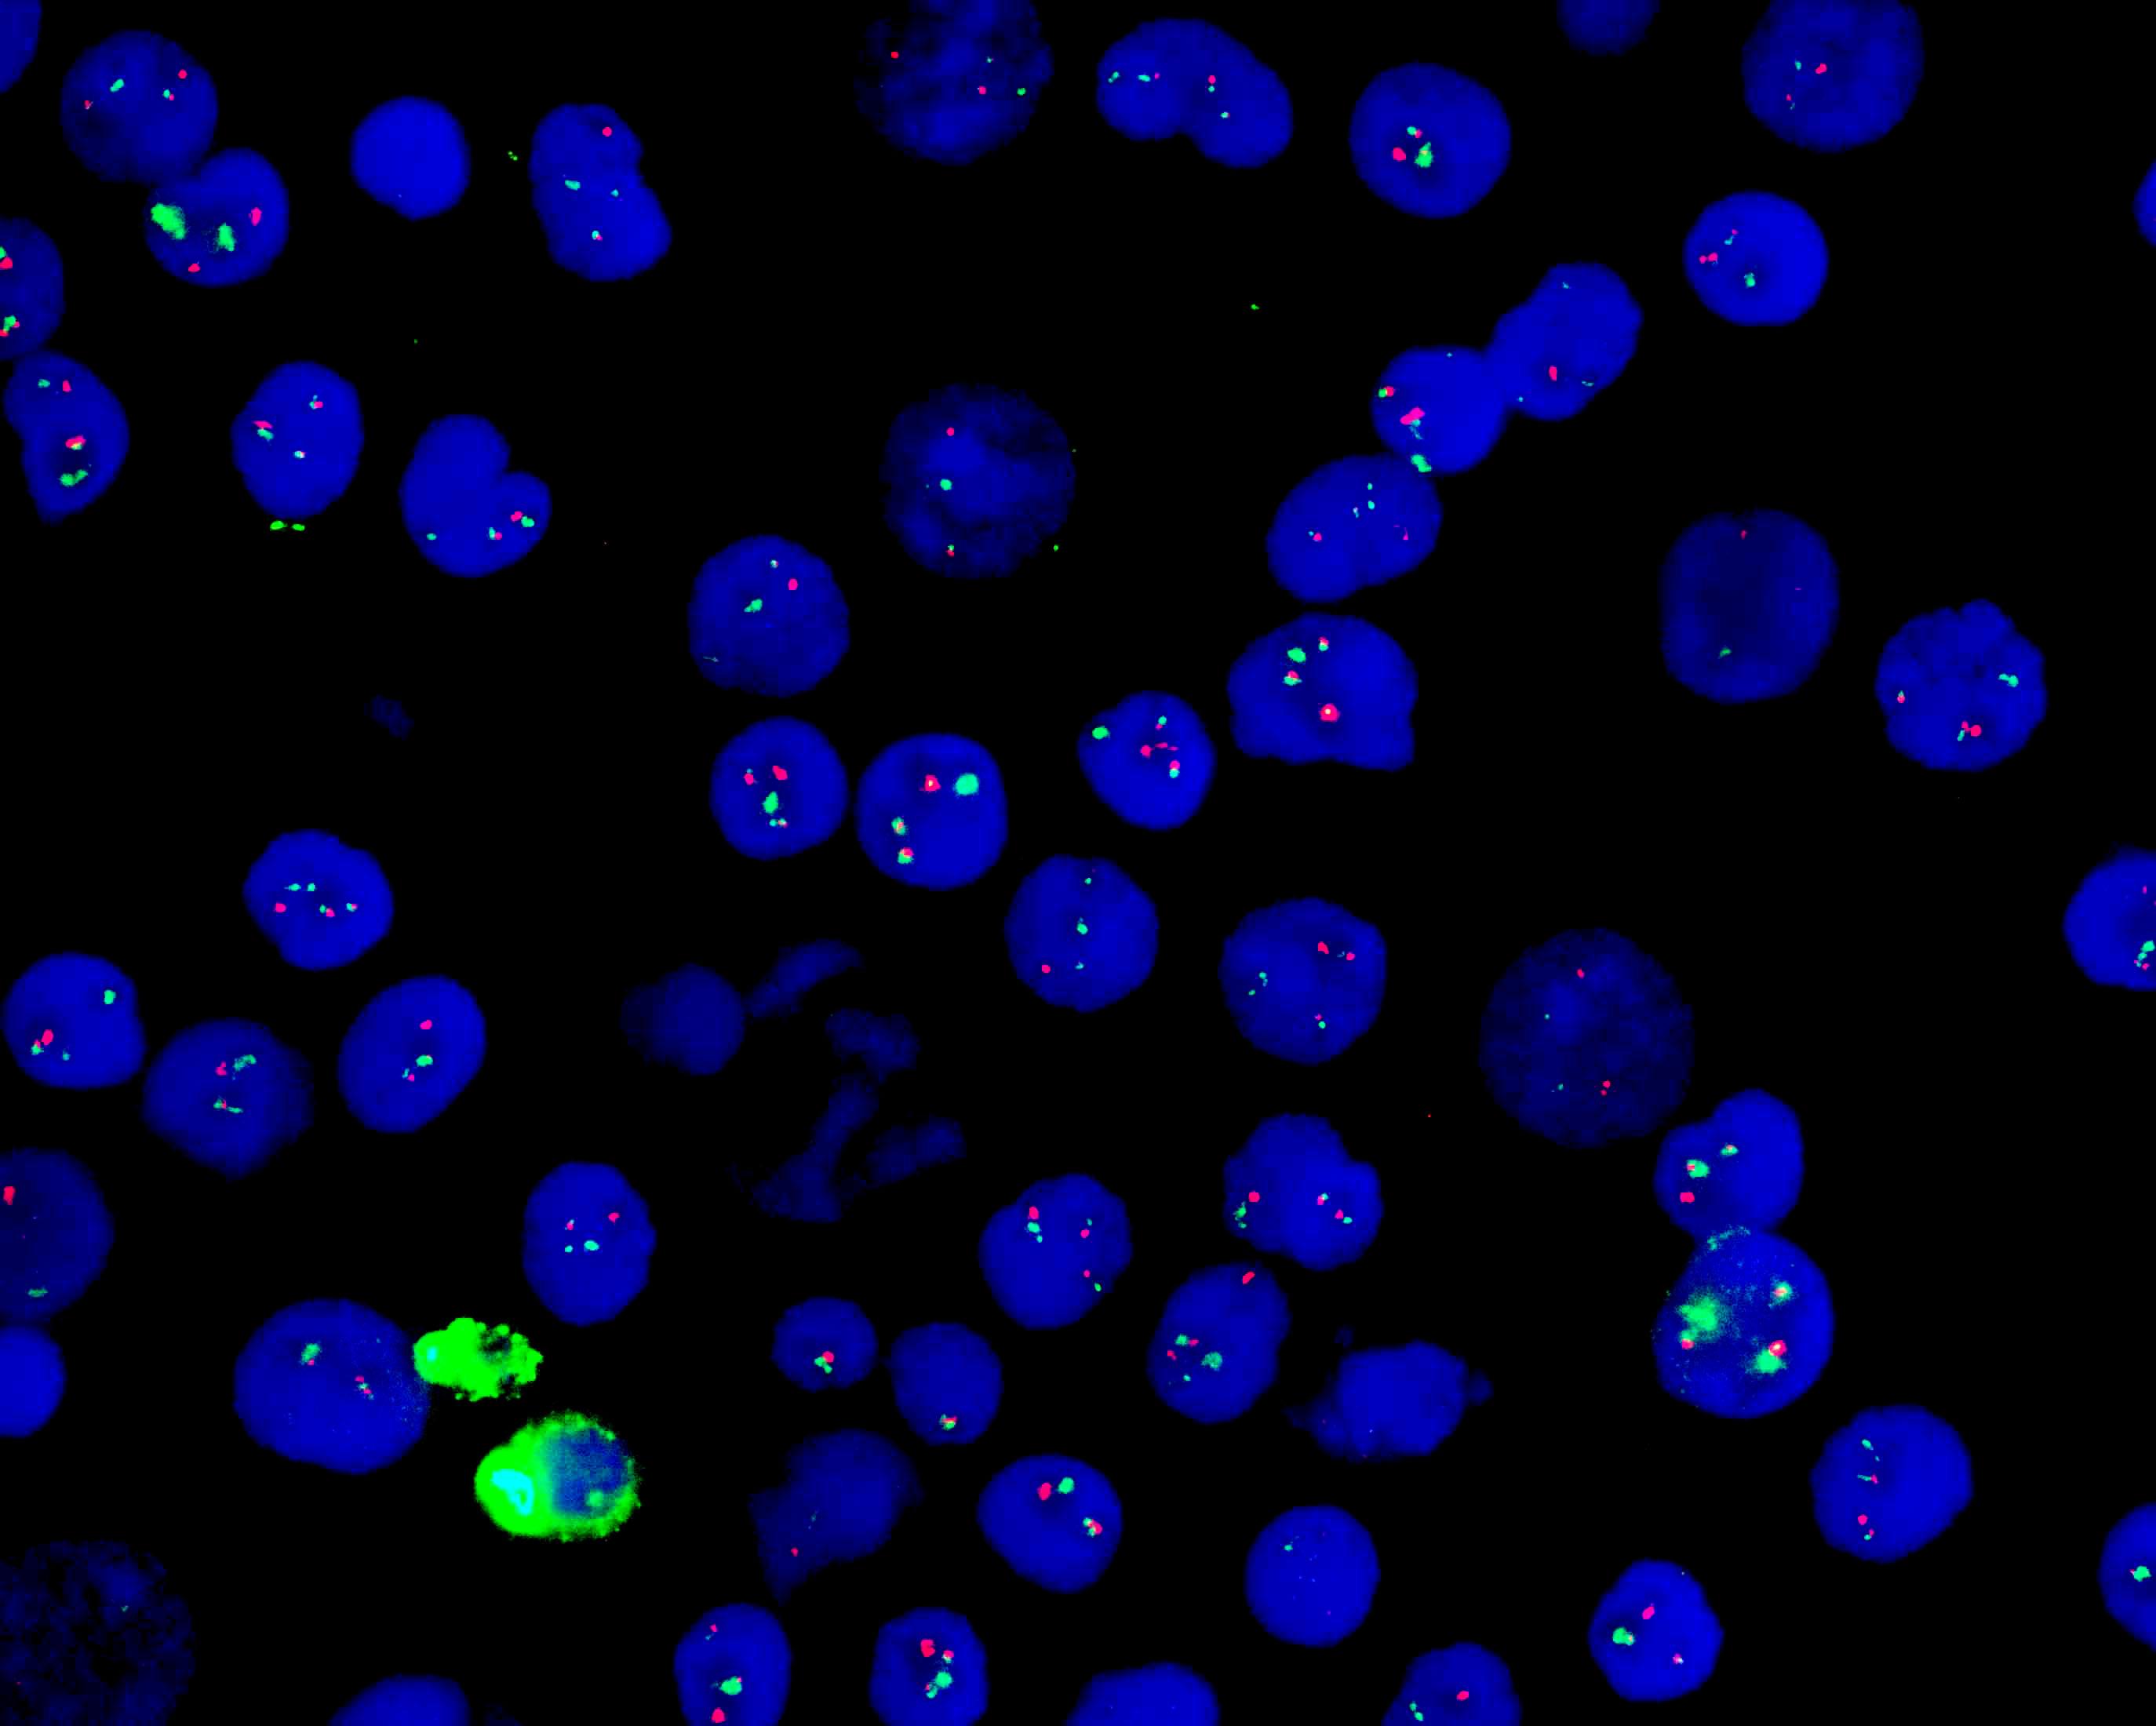
FP-003

BCR/ABL gene fusion detection kit
SKU: FP-003
BCR/ABL gene fusion detection kit
Regular,in stock
BCR/ABL dual color probe
Description:
ABL gene (9q34.11-13) labeled as orange, with a length of 600 kb; BCR gene (22q11.22-23) labeled as green, with a total length of 1000 kb.
Reference:
Hehne S, et al. (2012) Pathol Res Pract 208: 510-7. Lim TH, et al. (2005) Ann Acad Med Singapore 34: 533-8. Zheng X, et al. (2009) PLoS One 4: e7661. Exp Mol Pathol. 2006;81(1):1-7. Blood. 2021 Apr 29;137(17):2418. Ann Lab Med. 2018 Mar;38(2):169-171. J Environ Pathol Toxicol Oncol. 2018;37(2):117-126.